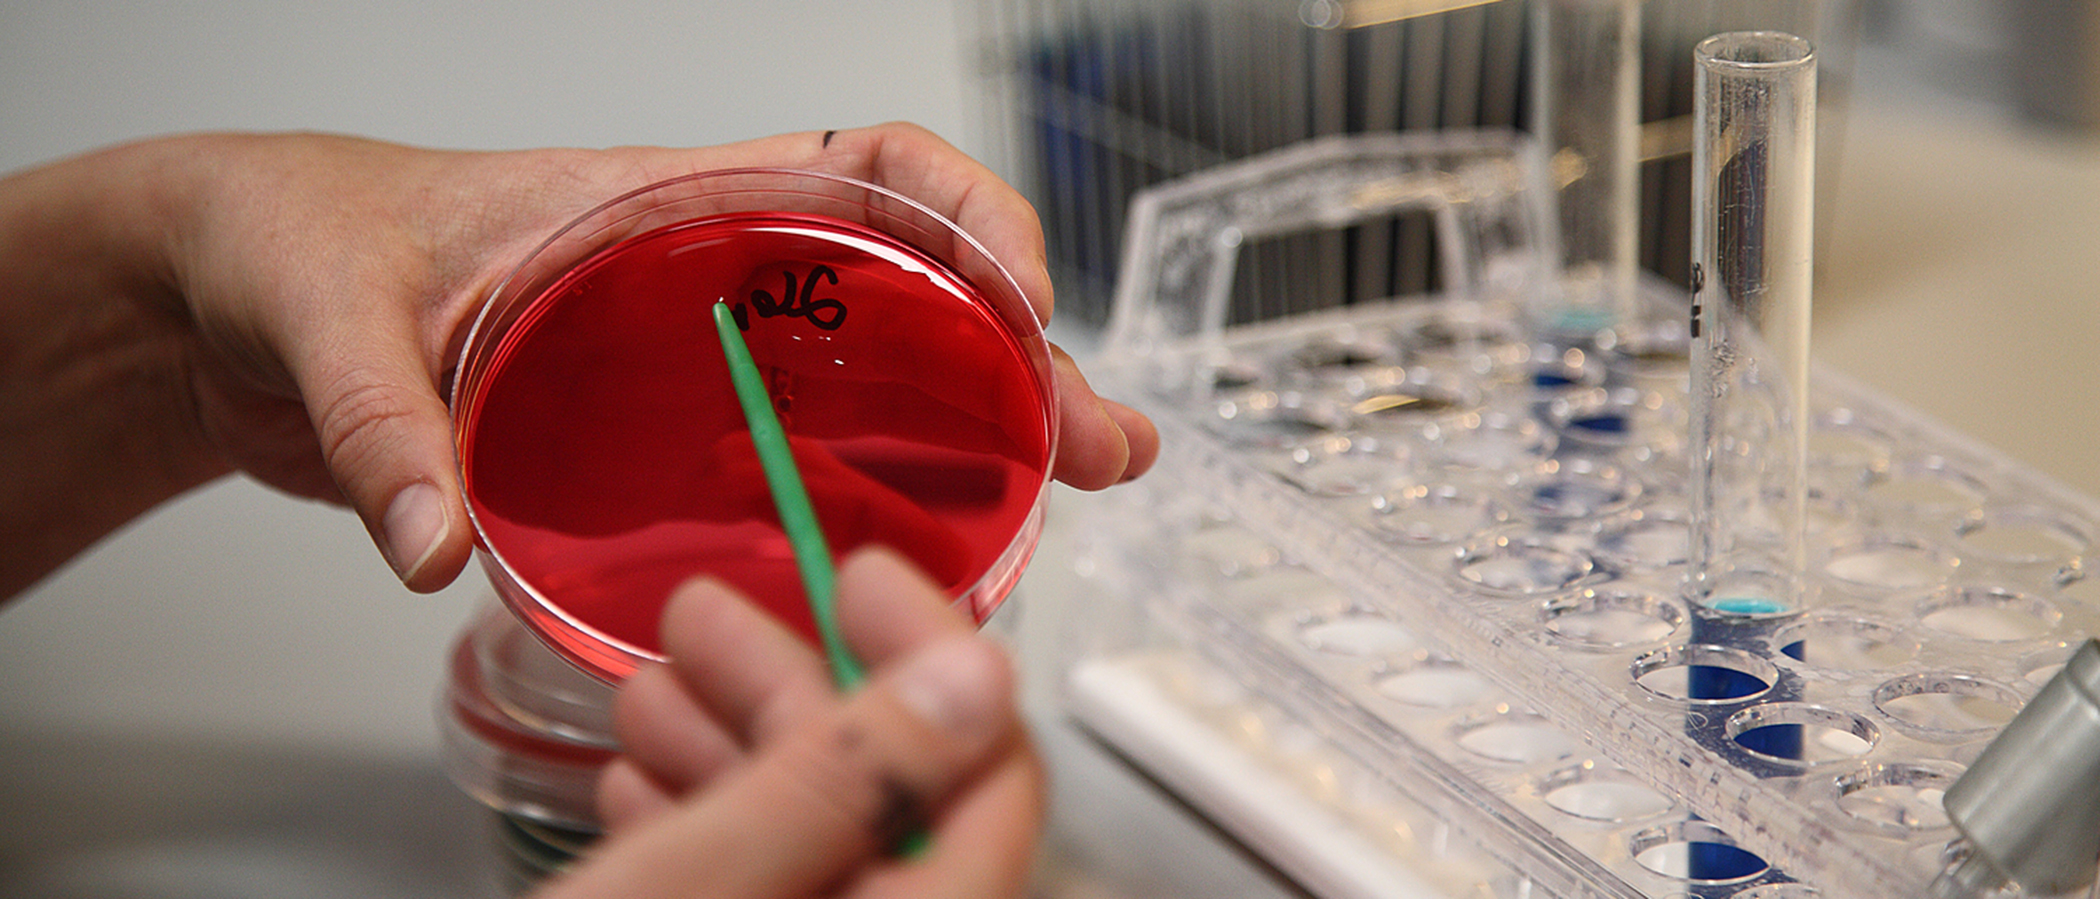
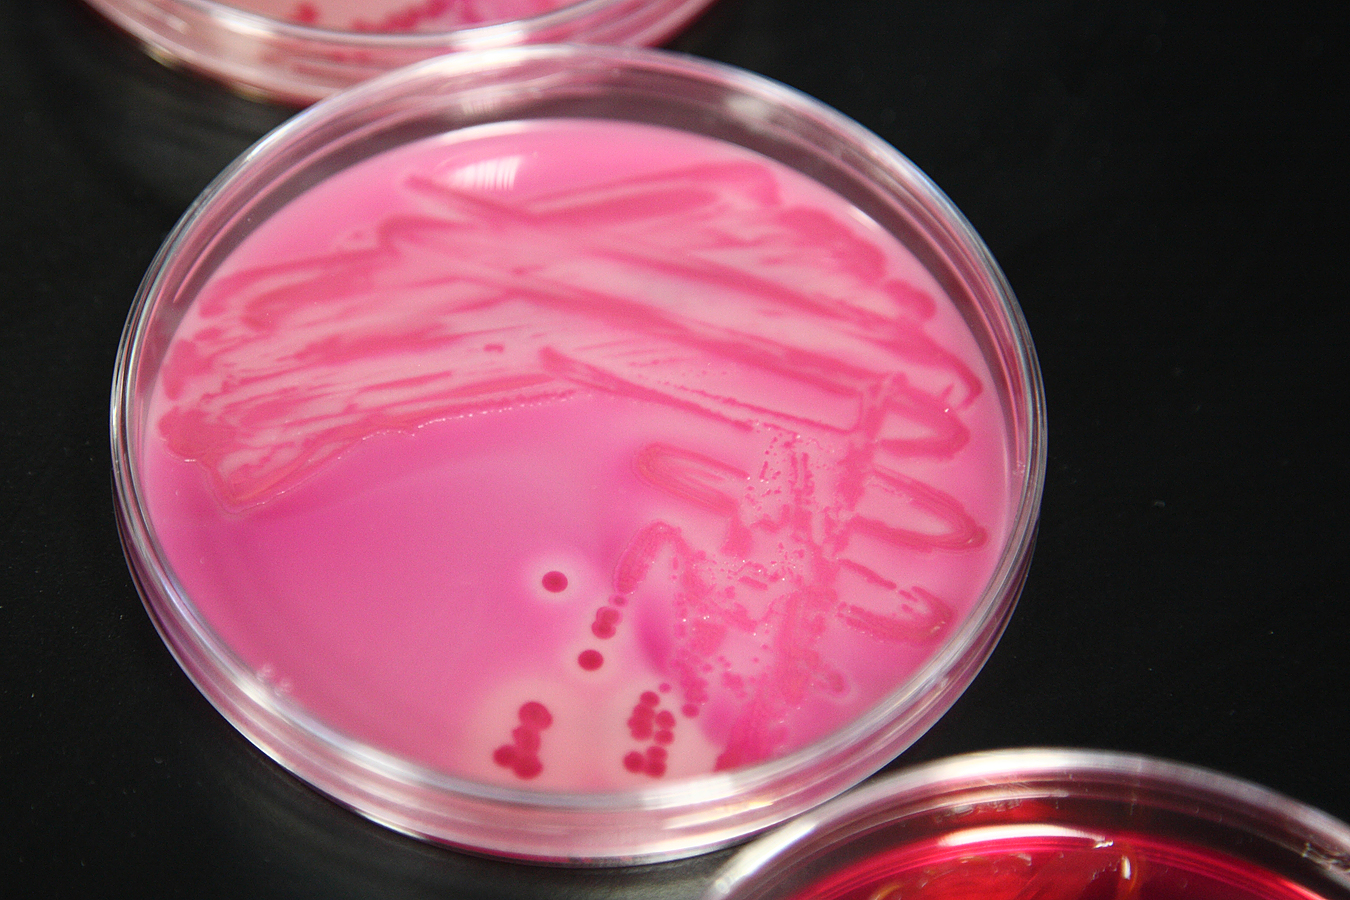

Olemme Suomessa tottuneet olemaan turvassa ruokamyrkytyksiltä.

Olemme Suomessa tottuneet olemaan turvassa ruokamyrkytyksiltä. Harva ymmärtää, kuinka poikkeuksellista se on – ja kuinka helposti voimme saavutetun etumme menettää.
1950-luvun Suomessa aloitettiin työ, jolla oli kauaskantoinen seuraus: Suomen kansainvälisesti verrattuna hyvin poikkeuksellinen salmonellatilanne. Salmonella on maailman yleisimpiä ruokamyrkytyksen aiheuttavia bakteereita, jonka esiintyvyys suomalaisessa ruokaketjussa on käytännössä olematon. Tuontituotteissa salmonellaa esiintyy jopa monikymmenkertaisesti.
”Olemme saaneet hävitettyä salmonellan elintarvikkeista lähes olemattomiin koko elintarvikeketjun kattavalla valvonnalla, tutkimuksella ja riskinarvioinnilla sekä tehokkaalla tuottajien ja viranomaisten välisellä yhteistyöllä”, yksikönjohtaja Pirkko Tuominen Ruokavirastosta toteaa.
Pelkkä suotuisa ilmasto ei meitä pelastanut. Kun muualla salmonellaan suhtauduttiin pitkään välttämättömänä kiusana, Suomessa valvonta ja tiukka nollatoleranssi aloitettiin jo 1950-luvulla. Tiloilla, teollisuudessa ja kaupassa tuotteista otetaan näytteitä ja niiden korkeaa tasoa valvotaan. Missä tahansa kohtaa tuotantoketjua salmonellaa todetaankin, ryhdytään toimenpiteisiin sen kukistamiseksi.

Salmonella on zoonoottinen bakteeri eli se voi tarttua eläimestä ihmiseen ja ihmisestä eläimeen. Tarkin valvonta ja raskaimmat toimenpiteet kohdistuvat tuotantoeläimiin. Salmonellaa kantavat eläimet ja niistä saatavat elintarvikkeet voidaan esimerkiksi asettaa karanteeniin.
Tuominen kertoo, että tilojen hygieniataso on pidetty Suomessa järjestelmällisesti korkeana. ”Myös eläin on sitä, mitä se syö, joten rehun laatu on tärkeää. Siksi meillä Suomessa valvotaan myös rehuja ja rehujen raaka-aineita salmonellan varalta. Rehua, jossa on salmonellaa, ei käytetä.”
Salmonella on suolistobakteeri eli se voi levitä ulosteen mukana. Siksi myös kasvien kasteluveden laadulla on merkitystä. Kun Suomessa sadetetaan, sekin tehdään järvien pintavedellä, joka on Suomessa puhtaampaa kuin monissa muissa maissa.
”Suomessa, Ruotsissa ja Norjassa vahditaan nykyään kaikkia salmonellan alalajeja eli serotyyppejä, muualla vain yleisimpiä. Salmonellan alalajejahan on yhteensä noin 2500”, Pirkko Tuominen muistuttaa.
Matkaa kohti nykyistä tilannetta on vauhdittanut myös suomalainen keksintö, kompetitiivinen ekskluusio. Tämän niin sanotun Nurmi-konseptin kehitti nykyisen Ruokaviraston edeltäjän Eviran edeltäjän Valtion eläinlääketieteellisen laitoksen johtaja ja professori Esko Nurmi työryhmineen 1970-luvun alussa. Idea oli yksinkertaisuudessaan nerokas: vastakuoriutuneet untuvikot altistettiin terveen kanan suolesta eristetyille mikrobeille.
Untuvikon suolistossa mikrobit valtasivat elintilan, jolloin salmonellat tai muut haitalliset bakteerit eivät pystyneet myöhemmin asettumaan sinne. Menetelmää on hyödynnetty Suomen broilerituotannossa menestyksekkäästi vuodesta 1976 lähtien.
Suomalaiset siivekkäät ovat siis hyötyneet ulosteensiirrosta jo kauan ennen kuin siitä tuli lupaava löytö ihmisten hoidossa.
Salmonella ei ole harmiton tauti. Euroopan elintarviketurvallisuusviranomainen EFSA on arvioinut salmonellan aiheuttavan kolmen miljardin euron vuosittaiset kustannukset EU:n alueella. Maailman terveysjärjestön WHO:n arvion mukaan salmonella aiheuttaa vuosittain 59 000 ihmisen kuoleman.
Suomalaisista noin 2 000 – 3 000 sairastuu vuodessa salmonellaan. Valtaosa taudeista on saatu ulkomailta ja vain noin 15 % tartunnoista on kotimaasta.
Suomalaiselle viennille salmonellattomuus on ollut kullanarvoinen ja luonut elintarvikekauppaan lisäarvoa. Myös suomalainen elintarviketurvallisuuden osaaminen kiinnostaa maailmalla.
Antibioottiresistenssin eli antibiooteille vastustuskykyisten bakteerien lisääntyminen tarkoittaa sitä, että eläimille annettavien antibioottien käyttöä pyritään vähentämään globaalisti. Kiinnostus Suomen osaamiseen salmonellan torjunnassa on lisääntynyt entisestään tämän takia.
”Esko Nurmen työryhmän kehittämä metodi on vähentänyt Suomessa broilereiden suolistobakteeritartuntoja. Menetelmä kaupallistettiin 1980-luvulla. Tämä osaaminen on todella arvokasta ja kiinnostaa muualla maailmassa”, professori Maria Fredriksson-Ahomaa Helsingin yliopistosta sanoo.
Viime vuosina koko Euroopan Unioni on alkanut taistella salmonellaa vastaan asettamalla tavoitteita salmonellan vähentämiseksi siipikarjassa, jota pidetään yhtenä suurimmista salmonellalähteistä. Myös ihmisillä raportoitujen salmonelloositapausten määrä EU:ssa on vähentynyt.
Nykyinen hyvä salmonellatilanne vaati kovaa ja pitkäjänteistä työtä. Suomen liittyessä Euroopan unioniin vuonna 1995 salmonellatilanteemme oli merkittävästi parempi kuin suurimmassa osassa jäsenmaita, minkä EU tunnusti myöntämällä Suomelle erityisvakuudet.

Suomi, Ruotsi ja Norja kehittivät tuolloin kukin kansallisen salmonellavalvontaohjelmansa, jonka avulla tuotantoeläinten salmonellatilannetta seurataan ja löydöksiin voidaan puuttua ripeästi. Näin salmonellatapausten määrä on saatu rajattua. Saimme myös neuvoteltua muista poikkeavat erityisvakuudet: Suomeen ei saa tuoda yhtään suoraan kulutukseen tarkoitettua liha- tai munaerää, jolle ei ole esittää todistusta salmonellattomuudesta.
Tuottajilta ja teollisuudelta ohjelma on edellyttänyt isoja taloudellisia panostuksia. Näytteitä otetaan säännöllisesti tuotantoketjun joka vaiheessa sekä myös rehuista – niin jalostuksessa, tuotannossa, teurastamossa kuin leikkaamossakin.
”Meillä on ollut salmonellavalvontaohjelman käynnistämisen jälkeen muutamia isoja rehuperäisiä epidemioita, mutta valvontaohjelman avulla ne saatu rajattua ja aisoihin tosi nopeasti. Kuluttajat ovat olleet turvassa, eikä heidän ole edes tarvinnut huomata tilannetta”, Tuominen kertoo.
Pirkko Tuomisen yksikkö arvioi Ruokavirastossa riskejä, jotka liittyvät elintarvikkeisiin ja zoonooseihin. Salmonellan tutkimisessa keskitytään Ruokavirastossa lähteiden jäljittämiseen. Entisaikojen tieteellinen salmonellakantojen tyypitystyö on muuttunut arkiseksi analytiikaksi vertailulaboratorioissa. Kunnianhimoisempaan työhön ei rahoitusta tunnu riittävän.
Tulevaisuudessa bakteerin lähde pystytään jäljittämään entistä paremmin, kun bakteereita pystytään tutkimaan geenitasolla. Kun lähde tiedetään, pystytään salmonellan aiheuttaja poistamaan ja riski eliminoimaan entistä tehokkaammin.
Salmonellaa kannattaisi Tuomisen mielestä tutkia nykyistä enemmän myös muista elintarvikeryhmistä, kuten tuontivihanneksista ja -hedelmistä.
Analytiikkaa tarvitaan myös elintarvikepetosten selvittämiseen. Ne ovat kasvanut riski, johon pelkkä papereiden tarkistaminen ei pure.
Ruokavirasto tekee salmonellan ehkäisyssä ja tutkimuksessa kiinteää yhteistyötä Helsingin yliopiston kanssa. Viime aikoina yliopiston tutkimus on keskittynyt erityisesti sikojen mahdolliseen altistumiseen salmonellainfektioille. Tutkijat ovat selvittäneet Ruokavirastolta saatujen verinäytteiden avulla myös sitä, millainen rooli villisioilla on salmonellan leviämisessä Suomessa.
”Villieläinpopulaatioita on syytä tutkia, sillä yli 40 prosenttia Suomessa tavatuista villisioista kantaa vasta-aineita salmonellalle ja on siten potentiaalisia tartuttajia”, Maria Fredriksson-Ahomaa sanoo.
Eniten villisikoja on Kaakkois-Suomessa, jossa kanta on kasvanut viime vuosina nopeasti. Satunnaisesti salmonellaa löytyy myös lemmikkikanoista ja koirista, jotka ovat saaneet salmonellabakteerin todennäköisesti villilintujen saastuttamasta ympäristöstä. Epidemiaksi nämä tartunnat eivät ole kasvaneet.
”Mutta Ruotsissa alkoi viime vuonna salmonellaepidemia villilinnuista, joiden kautta sen epäillään tarttuneen kissoihin ja kissoista ihmisiin”, Fredriksson-Ahomaa kertoo.

Fredriksson-Ahomaan mukaan Suomessa pitäisi tutkia enemmän ja kattavammin salmonellan mahdollisia lähteitä, mukaan lukien villieläimiä, sillä sitä kautta päästään kiinni tartuntareitteihin. Paremman kokonaiskuvan avulla riskinhallinta pystytään kohdistamaan tarkemmin ja tehokkaammin sinne, missä riski muodostuu.
Suurimpana haasteena salmonellan torjunnassa Fredriksson-Ahomaa pitää sitä tosiasiaa, että Suomi on osa globaalia yhteisöä. Suomi ei ole suljettu saareke, eikä salmonellan esiintyvyys ole pienenemässä.
”Kotimaisten elintarvikkeiden tilanne on hyvä, mutta ulkomaiset elintarvikkeet voivat sisältää salmonellaa, bakteeri voi levitä villi- ja tuotantoeläinten kontaktissa ja ihmiset tuovat salmonellaa ulkomaanmatkoiltaan. Vaikka tilanne on meillä kansainvälisessä vertailussa hyvä, tutkimusta pitää tehdä ja tilannetta seurata jatkuvasti.”
”Tietoa, taitoa ja tarvittava infrastruktuuri Suomessa on. Niiden lisäksi tarvitaan rahoitusta.”

Teksti: Johanna Pellinen ja Kati Toivanen
Pääkuva: Satu Hakola

Tarina on osa Tiede vaikuttaa! -kampanjaa, jonka toteuttavat yhdessä Suomen yliopistojen rehtorineuvosto UNIFI ja Tutkimuslaitosten yhteenliittymä Tulanet. Seuraa kampanjaa Twitterissä tunnisteella #tiedevaikuttaa ja jaa samalla oma tarinasi siitä, miten tiede on vaikuttanut sinun elämääsi.